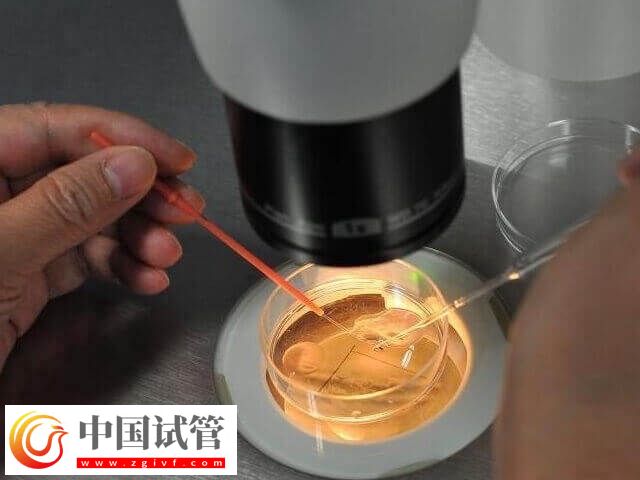
大齡試管嬰兒好孕經(jīng)驗(yàn)有哪些(圖1)

大齡試管嬰兒好孕經(jīng)驗(yàn)有哪些
試管嬰兒的成功率受到多方面因素的影響,包括但不限于夫婦雙方的年齡、身體健康狀況、備孕難的原因、生殖內(nèi)分泌醫(yī)生的臨床經(jīng)驗(yàn)、胚胎實(shí)驗(yàn)室的條件、胚胎師的專業(yè)技術(shù)水平,以及夫婦在治療過(guò)程中的依從性等。所以,在做試管嬰兒時(shí),心太、身體條件、醫(yī)院選擇等等都至關(guān)重要。
大齡試管嬰兒好孕經(jīng)驗(yàn)
眾所周知,大齡姐妹的試管之路與年輕姐妹相比,更為不易,但這并不意味著大齡女性就沒(méi)有生育機(jī)會(huì)!不信你看,下面這幾位大齡女性通過(guò)努力都收獲了好孕呢,所以她們希望將自己的試管經(jīng)驗(yàn)分享出去,讓更多的姐妹成功抱娃!
阿花:既然選擇了試管,就不要胡思亂想
自述
準(zhǔn)備做試管的時(shí)候我是迷茫的,經(jīng)常在網(wǎng)上搜試管嬰兒的相關(guān)信息,然后越看越亂,也不知道哪個(gè)是真哪個(gè)是假,害怕失敗,畢竟我這個(gè)歲數(shù)承受不起。包括移植后,我更是整天躺著不敢動(dòng),給自己特別大壓力,最后結(jié)果失敗了。但我不甘心,想著再試一次,最壞的結(jié)果也就是再失敗一次,要是放棄這輩子都沒(méi)機(jī)會(huì)了,第二次我慢慢調(diào)整了心態(tài),沒(méi)那么焦慮了,全程跟著醫(yī)生的步驟走,結(jié)果成功好孕。
經(jīng)驗(yàn)之談
做試管一定要調(diào)整好情緒,盡可能保持放松狀態(tài),嚴(yán)重焦慮會(huì)影響試管成功率。
莉娜:卵巢日漸衰退,珍惜每一顆卵子
自述
歲月不饒人,我是深有感觸,尤其是生育方面我真的有些力不從心,本來(lái)想著先好好調(diào)理卵巢,再開(kāi)始試管,這樣取到的卵子質(zhì)量可能也會(huì)好點(diǎn)。但醫(yī)生告訴我,做試管別拖延,尤其是大齡女性,本身卵巢功能已經(jīng)衰退了,再拖下去結(jié)果只會(huì)越來(lái)越差,沒(méi)有意義,只能說(shuō)一邊試管一邊調(diào)理,果然聽(tīng)醫(yī)生的話沒(méi)錯(cuò),在他的治療和引導(dǎo)下,我取到5顆卵子,雖然不多,但質(zhì)量都不錯(cuò),試管一次就成功了,真的太感謝了!
經(jīng)驗(yàn)之談
卵巢功能整體上是不可逆的,對(duì)于大齡女性而言必須爭(zhēng)分奪秒,珍惜每一顆卵子。
佳佳:胚胎移植前,身體也要檢查好
自述
我平時(shí)生活作息都很規(guī)律,所以身體素質(zhì)方面也還可以,試管過(guò)程中,直到取卵完成后,一切都很順利沒(méi)有太多波折,但沒(méi)想到的是,要移植的時(shí)候出現(xiàn)了問(wèn)題。移植前醫(yī)生建議給身體做個(gè)檢查,我本來(lái)認(rèn)為毫無(wú)意義的檢查,結(jié)果卻發(fā)現(xiàn)了輸卵管積水,而這個(gè)病直接會(huì)影響胚胎著床,所以只能先治療再移植了,現(xiàn)在想想也有些后怕,當(dāng)時(shí)要沒(méi)檢查,可能也不會(huì)一次好孕。
經(jīng)驗(yàn)之談
胚胎移植前,該做的檢查一定要做,只有身體在好的條件下,胚胎才能順利著床。
小李:有資質(zhì)的醫(yī)院,是選擇的前提
自述
對(duì)于大齡的我而言,沒(méi)有太多試錯(cuò)成本,所以選擇醫(yī)院的時(shí)候比較謹(jǐn)慎,起碼得有試管資質(zhì),有好的醫(yī)生,滿足這倆條件做起試管我才會(huì)放心,經(jīng)過(guò)多方的比較和了解,我選擇了有口皆碑的家圓(當(dāng)然這里不是打廣告啊,是真心推薦),選擇了一家好醫(yī)院,一切得心應(yīng)手,醫(yī)生也根據(jù)我的情況定制了適合的方案,結(jié)果證明我的選擇沒(méi)有錯(cuò)。
經(jīng)驗(yàn)之談
一個(gè)好的醫(yī)院,會(huì)給大齡女性生育更多的機(jī)會(huì),所以大家一定要慎重考慮。





